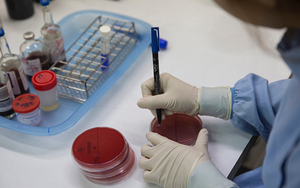
Tế bào máu nuôi cấy trong phòng thí nghiệm lần đầu tiên được truyền vào cơ thể người

Tag máu trong phòng thí nghiệm
Tế bào máu nuôi cấy trong phòng thí nghiệm lần đầu tiên được truyền vào cơ thể người
Đầu tháng 11 vừa qua, các nhà khoa học Anh đã tiến hành truyền một lượng nhỏ máu nuôi cấy trong phòng thí nghiệm cho hai bệnh nhân. Đây là cuộc thử nghiệm đầu tiên trên thế giới về phương pháp này.
 Thời tiết
Thời tiết
Hà Nội
-
An Giang
-
Bình Dương
-
Bình Phước
-
Bình Thuận
-
Bình Định
-
Bạc Liêu
-
Bắc Giang
-
Bắc Kạn
-
Bắc Ninh
-
Bến Tre
-
Cao Bằng
-
Cà Mau
-
Cần Thơ
-
Điện Biên
-
Đà Nẵng
-
Đà Lạt
-
Đắk Lắk
-
Đắk Nông
-
Đồng Nai
-
Đồng Tháp
-
Gia Lai
-
Hà Nội
-
TP Hồ Chí Minh
-
Hà Giang
-
Hà Nam
-
Hà Tĩnh
-
Hòa Bình
-
Hưng Yên
-
Hải Dương
-
Hải Phòng
-
Hậu Giang
-
Khánh Hòa
-
Kiên Giang
-
Kon Tum
-
Lai Châu
-
Long An
-
Lào Cai
-
Lâm Đồng
-
Lạng Sơn
-
Nam Định
-
Nghệ An
-
Ninh Bình
-
Ninh Thuận
-
Phú Thọ
-
Phú Yên
-
Quảng Bình
-
Quảng Nam
-
Quảng Ngãi
-
Quảng Ninh
-
Quảng Trị
-
Sóc Trăng
-
Sơn La
-
Thanh Hóa
-
Thái Bình
-
Thái Nguyên
-
Thừa Thiên Huế
-
Tiền Giang
-
Trà Vinh
-
Tuyên Quang
-
Tây Ninh
-
Vĩnh Long
-
Vĩnh Phúc
-
Vũng Tàu
-
Yên Bái







